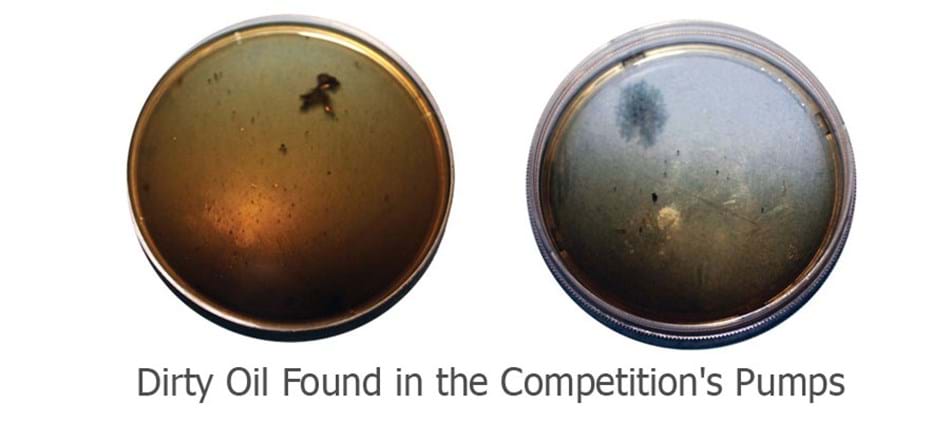

Diesel High Pressure Oil Pumps
The High Pressure Oil Pump (HPOP) delivers high pressure oil to the fuel injectors, which operate hydraulically. To ensure superior performance, our Diesel High Pressure Oil Pumps are the product of an in-depth remanufacturing process that includes inspection, tear down and validation, cleaning, reassembly, and testing.
High Pressure Oil Pump Replacement - 2002 Ford F-250 7.3L Powerstroke
Watch for helpful tips on replacing the High Pressure Oil Pump on your F-250 with a 7.3L Powerstroke engine
Interested in learning more about installing this product? Check out the SMP Knowledge Center.
Dirty Oil and Other Issues Found in The Competition's Pumps
We disassembled and inspected diesel high pressure oil pumps from the competition. Here’s what we found:
- Paint on areas of housing that are subject to engine oil
- Reused core components including check valve assemblies, check springs, plunger return springs, and camshaft followers
- Rust in check valve assembly bores, stuck check balls in the housing, and dirty oil in pumps
Us vs. The Competition
All BWD® Diesel High Pressure Oil Pumps are the product of an exhaustive remanufacturing process at our TS16949, ISO9001, and ISO14001 certified facility. Throughout our process, our pumps and components are inspected, torn down and validated, cleaned, reassembled, and tested, so you can install our part with confidence. Take the process for our 37506, for example:
-

Camshaft Followers
We perform a 100% inspection on all camshaft followers and replace them with new wherever required.
-

Drive Gear
We inspect and clean each drive gear before reusing.
-

High-Pressure Discharge Fitting
We install 100% new, updated high-pressure discharge fittings and torque them to factory specifications and the correct orientation to prevent leakage.
-

Bearings
We perform a 100% inspection of both front and rear bearings. If the core bearings are bad, we replace them with 100% new bearings that are the product of a line boring/honing process.
-

Check Valve Assembly
We reassemble every check valve assembly with new sleeves, plugs, check springs, and machine-lapped flangers and plates.
-

Housing
We paint the exposed topside of the pump to prevent rusting. We don't paint the rest of the housing to prevent exposing the engine oil to paint contamination.
